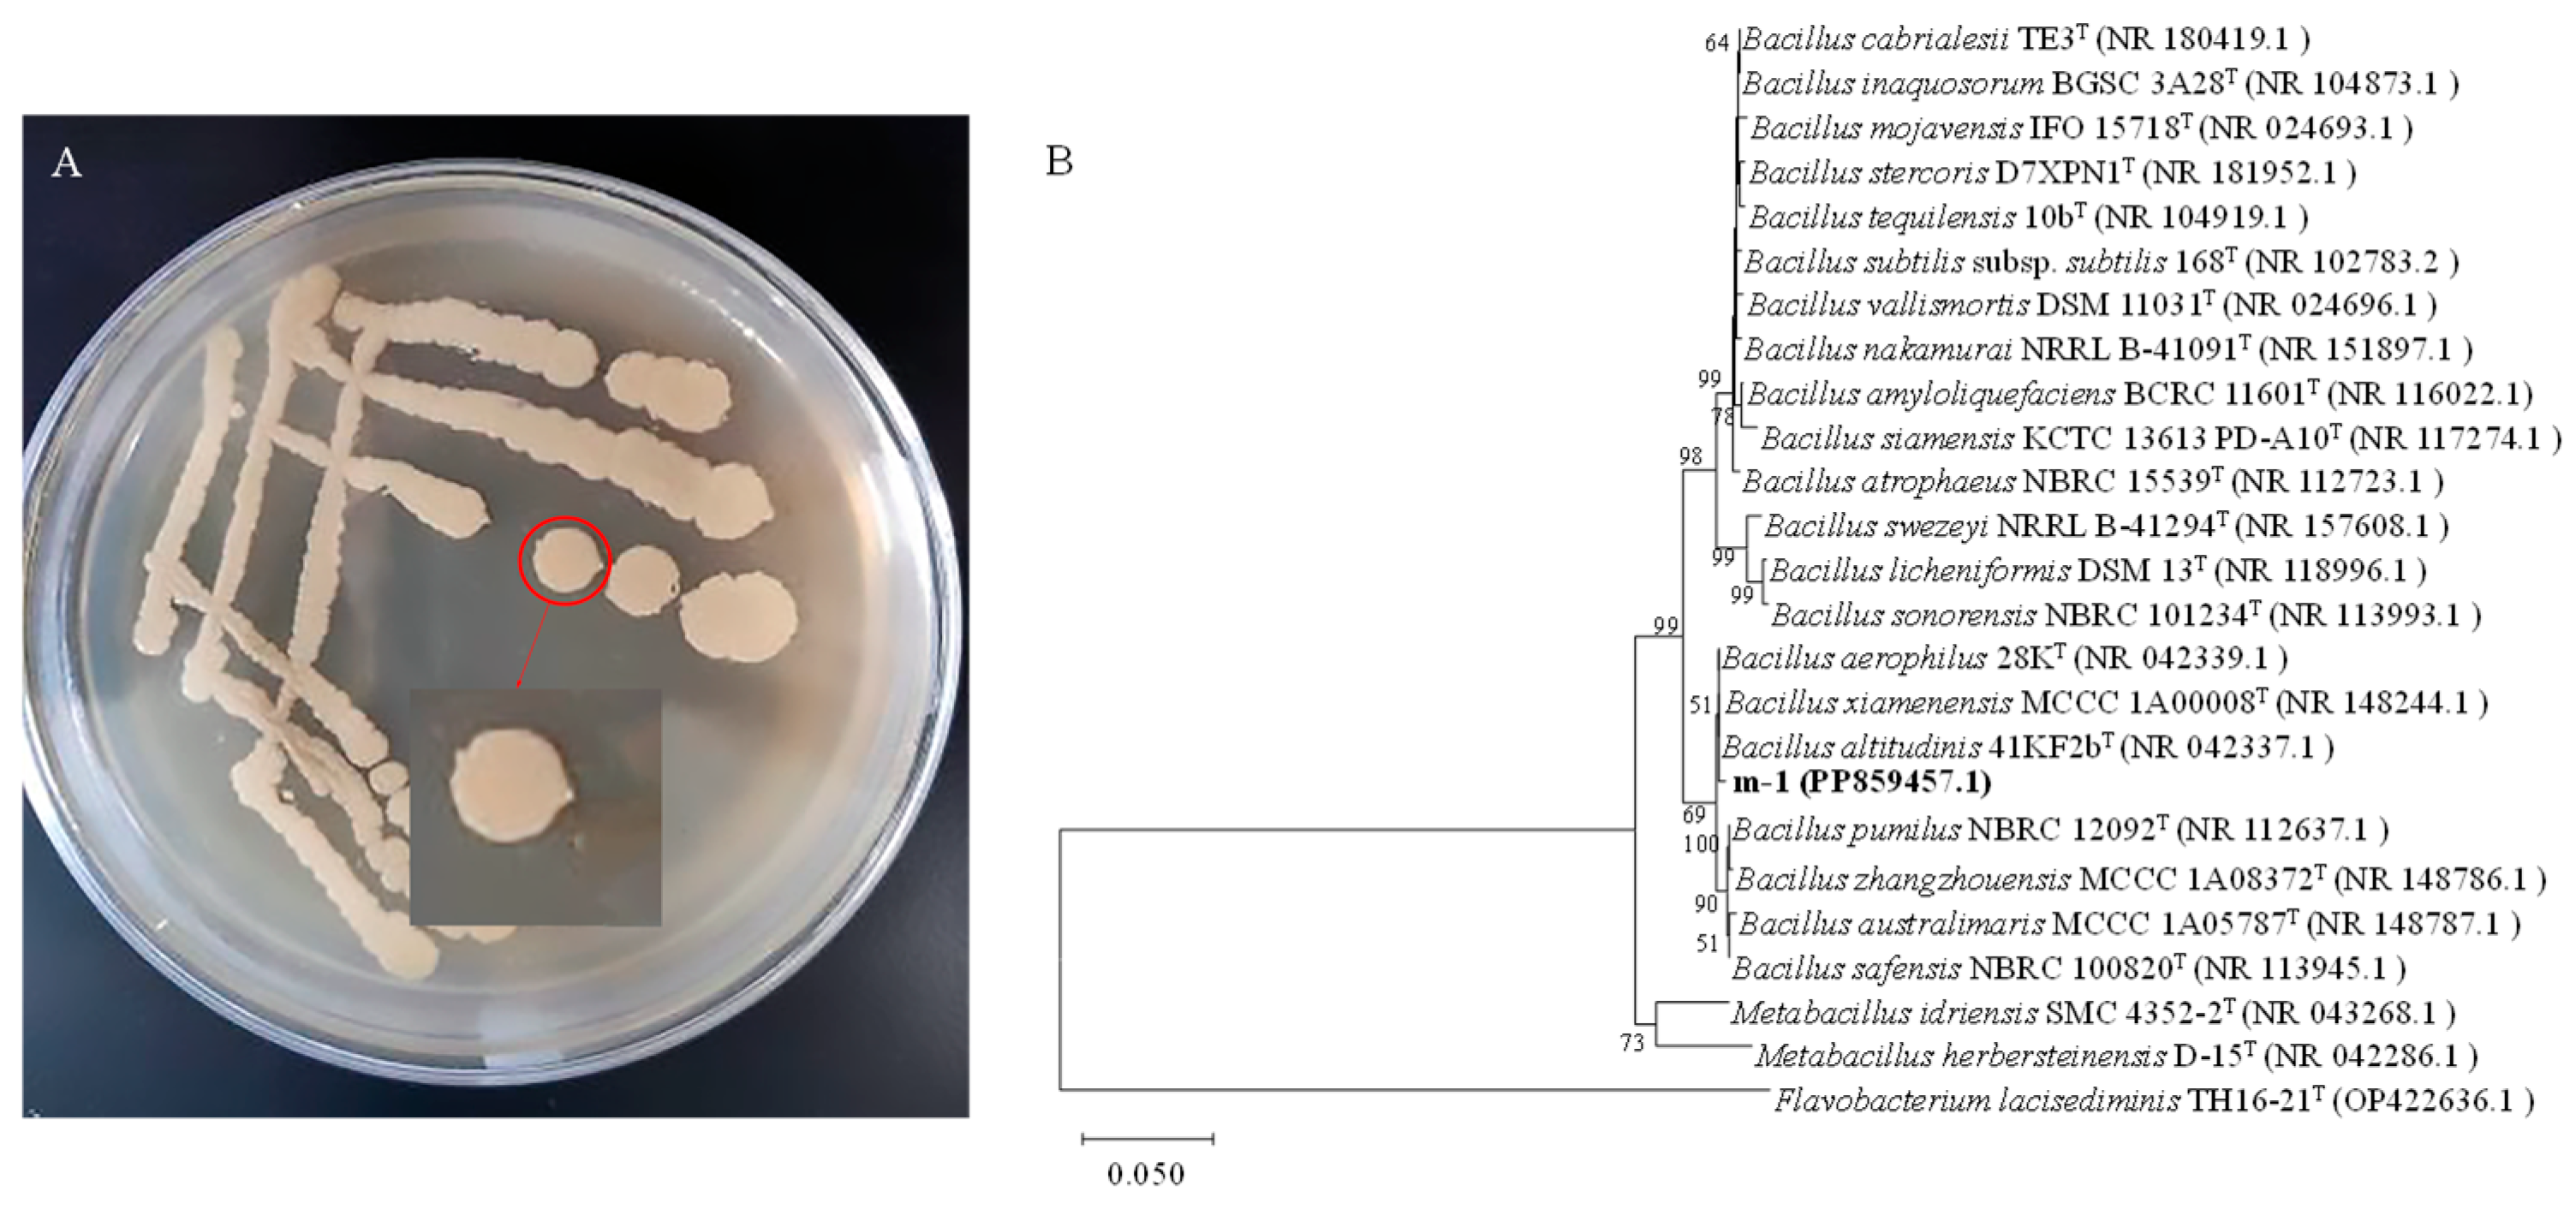
Ijms 25 08872 g002

Antagonistic Strain Bacillus velezensis JZ Mediates the Biocontrol of Bacillus altitudinis m-1, a Cause of Leaf Spot Disease in Strawberry
Abstract
1. Introduction
2. Results
2.1. Isolation and Identification of B. velezensis JZ and B. altitudinis m-1
2.2. Assessment of the Inhibitory Activity of JZ Against m-1
2.3. Determination of the Minimum Inhibitory Concentration (MIC) of Crude Extract and Optimization of the Extraction Method
2.4. Effect of Crude Extract on the Permeability and Ca2+-ATPase Activity of m-1 Cell Membranes
2.5. Effect of Crude Extracts on Intracellular Rreactive Oxygen Species (ROS) and Superoxide Dismutase (SOD) Activity in m-1 Cells
2.6. Semi-Preparative High-Performance Liquid Chromatography (HPLC) and Quadrupole Time-of-Flight/Tandem Mass Spectrometry (QTOF-MS/MS) of Substances with Antagonistic Activity in the JZ Crude Extract
3. Discussion
4. Materials and Methods
4.1. Isolation and Identification of B. velezensis JZ and B. altitudinis m-1
4.2. Identification of the Inhibitory Activity of JZ Cells against m-1 Cells
4.3. Determination of the Antibacterial Activity of Crude Extracts and Optimization of the Extraction Method
4.3.1. Optimization of pH in Acid Precipitation
4.3.2. Optimization of Fermentation Time and Activity Determination of Crude Extracts
4.4. Minimum Inhibitory Concentration of Crude Extract on m-1 Cells
4.5. Effect of Crude Extract on the Permeability of m-1 Cell Membranes
4.6. Effect of Crude Extract on m-1 Cell Membrane Ca2+-ATPase Activity
4.6.1. Preparation of the Reaction System
4.6.2. Detection of Enzyme Activity
4.7. Effect of Crude Extracts on Intracellular ROS in m-1 Cells
4.8. Effect of Crude Extract on Intracellular SOD Activity in m-1 Cells
4.9. Identification of Substances in Crude Extracts
Author Contributions
Funding
Institutional Review Board Statement
Informed Consent Statement
Data Availability Statement
Conflicts of Interest
References
- Yi, Y.; Luan, P.; Wang, K.; Li, G.; Yin, Y.; Yang, Y.; Zhang, Q.; Liu, Y. Antifungal activity and plant growth-promoting properties of Bacillus mojovensis B1302 against Rhizoctonia Cerealis. Microorganisms 2022, 10, 1682. [Google Scholar] [CrossRef] [PubMed]
- Biswas, S.; Philip, I.; Jayaram, S.; Sarojini, S. Endophytic bacteria Klebsiella spp. and Bacillus spp. from Alternanthera philoxeroides in Madiala Lake exhibit additive plant growth-promoting and biocontrol activities. J. Genet. Eng. Biotechnol. 2023, 21, 153. [Google Scholar] [CrossRef] [PubMed]
- Patani, A.; Patel, M.; Islam, S.; Yadav, V.K.; Prajapati, D.; Yadav, A.N.; Sahoo, D.K.; Patel, A. Recent advances in Bacillus-mediated plant growth enhancement: A para-digm shift in redefining crop resilience. World J. Microbiol. Biotechnol. 2024, 40, 77. [Google Scholar] [CrossRef] [PubMed]
- Adamo, I.; Acin-Albiac, M.; Röttjers, S.; de Prado, D.R.; Benito, B.M.; Zamora, J.; Go-dara, R.; García-Jiménez, B.; Jiang-Rempel, P.; Cline, L.C.; et al. Short impact on soil microbiome of a Bacillus amyloliquefaciens QST713 based product that correlates with higher potato yield across USA. Front. Plant Sci. 2024, 15, 1332840. [Google Scholar] [CrossRef] [PubMed]
- Naher, U.A.; Biswas, J.C.; Maniruzzaman, M.; Khan, F.H.; Sarkar, M.I.U.; Jahan, A.; Hera, M.H.R.; Hossain, M.B.; Islam, A.; Islam, M.R.; et al. Bio-organic fertilizer: A green technology to reduce synthetic N and P fertilizer for rice production. Front. Plant Sci. 2021, 12, 602052. [Google Scholar] [CrossRef] [PubMed]
- Khalid, F.; Khalid, A.; Fu, Y.C.; Hu, Q.; Zheng, Y.F.; Khan, S.; Wang, Z.G. Potential of Bacillus velezensis as a probiotic in animal feed: A review. J. Microbiol. 2021, 59, 627–633. [Google Scholar] [CrossRef]
- Chen, M.M.; Chen, L.Z. Study on plant bacterial diseases and its prevention and control measures. J. Zhejiang Agric. Sci. 2022, 63, 1798–1804. [Google Scholar]
- Liu, C.G.; Wang, Q.; Bian, Y.B.; Xiao, Y. Research progress on bacterial diseases of major edible mushrooms. Edible Med. Mushrooms 2022, 30, 36–42. [Google Scholar]
- Ruiz-García, C.; Béjar, V.; Martínez-Checa, F.; Llamas, I.; Quesada, E. Bacillus velezensis sp. nov., a surfactant-producing bacterium isolated from the river Velez in Malaga, southern Spain. Int. J. Syst. Evol. Microbiol. 2005, 55, 191–195. [Google Scholar] [CrossRef]
- Zhang, D.; Yu, S.; Zhao, D.; Zhang, J.; Pan, Y.; Yang, Y.; Yang, Z.; Zhu, J.; Zhao, Y.; Li, R. Inhibitory effects of non-volatiles lipopeptides and volatiles ketones metabolites secreted by Bacillus velezensis C16 against Alternaria solani. Biol. Control 2021, 152, 104421. [Google Scholar] [CrossRef]
- Devi, S.; Kiesewalter, H.T.; Kovács, R.; Frisvad, J.C.; Weber, T.; Larsen, T.O.; Kovács, Á.T.; Ding, L. Depiction of secondary metabolites and antifungal activity of Bacillus velezensis DTU001. Synth. Syst. Biotechnol. 2019, 4, 142–149. [Google Scholar] [CrossRef] [PubMed]
- Wang, C.; Ye, X.; Ng, T.B.; Zhang, W. Study on the biocontrol potential of antifungal peptides produced by Bacillus velezensis against Fusarium solani that infects the passion fruit Passiflora edulis. J. Agric. Food Chem. 2021, 69, 2051–2061. [Google Scholar] [CrossRef] [PubMed]
- Cui, L.; Yang, C.; Wei, L.; Li, T.; Chen, X. Solation and identification of an endophytic bacteria Bacillus velezensis 8-4 exhibiting biocontrol activity against potato scab. Biol. Control 2020, 141, 104156. [Google Scholar] [CrossRef]
- Calvo, H.; Mendiara, I.; Arias, E.; Gracia, A.P.; Blanco, D.; Venturini, M.E. Antifungal activity of the volatile organic compounds produced by Bacillus velezensis strains against postharvest fungal pathogens. Postharvest Biol. Technol. 2020, 166, 111208. [Google Scholar] [CrossRef]
- Liu, Q.; Li, D.; Hu, H.; Huang, Q.; Zhang, Y.; Zhou, F.; Song, P.; Guan, Y.; Bu, R.; Hu, P.; et al. First report of Bacillus altitudinis causing seed rot of pomegranate in China. Australas. Plant Pathol. 2021, 50, 427–429. [Google Scholar] [CrossRef]
- Goswami, M.; Deka, S. Biosurfactant production by a rhizosphere bacteria Bacillus altitudinis MS16 and its promising emulsification and antifungal activity. Colloids Surf. B Biointerfaces 2019, 178, 285–296. [Google Scholar] [CrossRef]
- Sunar, K.; Dey, P.; Chakraborty, U.; Chakraborty, B. Biocontrol efficacy and plant growth promoting activity of Bacillus altitudinis isolated from Darjeeling hills, India. J. Basic Microbiol. 2015, 55, 91–104. [Google Scholar] [CrossRef] [PubMed]
- Kumvinit, A.; Akarapisan, A. Characterization of blackleg and soft rot from potato in northern Thailand. J. Phytopathol. 2019, 167, 655–666. [Google Scholar] [CrossRef]
- Elbanna, K.; Elnaggar, S.A.; Bakeer, A.T. Characterization of Bacillus altitudinis as a new causative agent of bacterial soft rot. J. Phytopathol. 2014, 162, 712–722. [Google Scholar] [CrossRef]
- Lemjiber, N.; Naamani, K.A.; Mérieau, A.; Dihazi, A.; Zhar, N.; Jediyi, H.; Boukerb, A.M. Identification and genomic characterization of pathogenic Bacillus altitudinis from common pear trees in Morocco. Agronomy 2021, 11, 1344. [Google Scholar] [CrossRef]
- Afsharmanesh, H.; Ahmadzadeh, M. The iturin lipopeptides as key compounds in antagonism of Bacillus subtilis UTB96 toward Aspergillus flavus. Biol. Control Pests Plant Dis. 2016, 5, 79–95. [Google Scholar]
- Wang, R.; Wang, C.; Zuo, B.; Liang, X.; Zhang, D.; Liu, R.; Yang, L.; Lu, B.; Wang, X.; Gao, J. A novel Biocontrol Strain Bacillus amyloliquefaciens FS6 for Excellent Control of Gray Mold and Seedling Diseases of Ginseng. Plant Dis. 2021, 105, 1926–1935. [Google Scholar] [CrossRef] [PubMed]
- Biemer, J.J. Antimicrobial susceptibility testing by the Kirby-Bauer disc diffusion method. Ann. Clin. Lab. Sci. 1973, 3, 135–140. [Google Scholar] [PubMed]
- Toral, L.; Rodríguez, M.; Béjar, V.; Sampedro, I. Antifungal activity of lipopeptides from Bacillus XT1 CECT 8661 against botrytis cinerea. Front. Microbiol. 2018, 9, 1315. [Google Scholar] [CrossRef] [PubMed]
- Zhao, H.; Li, J.; Zhang, Y.; Lei, S.; Zhao, X.; Shao, D.; Jiang, C.; Shi, J.; Sun, H. Potential of iturins as functional agents: Safe, probiotic, and cytotoxic to cancer cells. Food Funct. 2018, 9, 5580–5587. [Google Scholar] [CrossRef]
- Xu, Z.; Zhang, R.; Wang, D.; Qiu, M.; Feng, H.; Zhang, N.; Shen, Q. Enhanced control of cucumber wilt disease by Bacillus amyloliquefciens SQR9 by altering the regulation of Its DegU phosphorylation. Appl. Environ. Microbiol. 2014, 80, 2941–2950. [Google Scholar] [CrossRef] [PubMed]
- Banerjee, S.; Sen, S.; Bhakat, A.; Bhowmick, A.; Sarkar, K. The lipopeptides fengycin and iturin are involved in the anticandidal activity of endophytic Bacillus sp. asdetermined by experimental and in silico analysis. Lett. Appl. Microbiol. 2022, 75, 450–459. [Google Scholar] [CrossRef]
- Arrebola, E.; Jacobs, R.; Korsten, L. Iturin A is the principal inhibitor in the biocontrol activity of Bacillus amyloliquefaciens PPCB004 against postharvest fungal pathogens. J. Appl. Microbiol. 2010, 108, 386–395. [Google Scholar] [CrossRef]
- Lam, V.B.; Meyer, T.; Arias, A.A.; Ongena, M.; Oni, F.E.; Höfte, M. Bacillus cyclic lipopeptides iturin and fengycin control rice blast Caused by Pyricularia oryzae in potting and acid sulfate soils by direct antagonism and induced systemic resistance. Microorganisms 2021, 9, 1441. [Google Scholar] [CrossRef]
- Fan, H.; Ru, J.; Zhang, Y.; Wang, Q.; Li, Y. Fengycin produced by Bacillus subtilis 9407 plays a major role in the biocontrol of apple ring rot disease. Microbiol. Res. 2017, 19, 89–97. [Google Scholar] [CrossRef]
- Chen, L.; Heng, J.; Qin, S.; Bian, K. A comprehensive understanding of the biocontrol potential of Bacillus velezensis LM2303 against Fusarium head blight. PLoS ONE 2018, 13, e0198560. [Google Scholar] [CrossRef]
- Wang, B.; Yang, B.; Peng, H.; Lu, J.; Fu, P. Genome sequence and comparative analysis of fungal antagonistic strain Bacillus velezensis LJBV19. Folia Microbiol. 2023, 68, 73–86. [Google Scholar] [CrossRef] [PubMed]
- Xu, T.; Zhu, T.; Li, S. β-1,3-1,4-glucanase gene from Bacillus velezensis ZJ20 exerts antifungal effect on plant pathogenic fungi. World J. Microbiol. Biotechnol. 2016, 32, 26. [Google Scholar] [CrossRef] [PubMed]
- Zhang, S.B.; Qin, Y.L.; Li, S.F.; Lv, Y.Y.; Zhai, H.C.; Hu, Y.S.; Cai, J.P. Antifungal mechanism of 1-nonanol against Aspergillus flavus growth revealed by metabolomic analyses. Appl. Microbiol. Biotechnol. 2021, 105, 7871–7888. [Google Scholar] [CrossRef] [PubMed]
- Huda, K.M.; Banu, M.S.; Garg, B.; Tula, S.; Tuteja, R.; Tuteja, N. OsACA6, a P-type IIB Ca2+-ATPase promotes salinity and drought stress tolerance in tobacco by ROS scavenging and enhancing the expression of stress-responsive genes. Plant J. 2013, 76, 997–1015. [Google Scholar] [CrossRef] [PubMed]
- Kang, K.; Fan, J.M.; Chen, L.L.; Zhang, H.T.; Lei, Y.; Hu, Y.S. Biocontrol potential and mechanism of action of Bacillus tequilensis JK-11 against wheat root rot disease. Eur. J. Plant Pathol. 2024, 169, 867–885. [Google Scholar] [CrossRef]
- Zhao, H.; Liu, K.; Fan, Y.; Cao, J.; Li, H.; Song, W.; Liu, Y.; Miao, M. Cell-free supernatant of Bacillus velezensis suppresses mycelial growth and reduces virulence of Botrytis cinerea by inducing oxidative stress. Front. Microbiol. 2022, 13, 980022. [Google Scholar] [CrossRef] [PubMed]
- Xu, W.; Wang, H.; Lv, Z.; Shi, Y.; Wang, Z. Antifungal activity and functional components of cell-free supernatant from Bacillus amyloliquefaciens LZN01 inhibit Fusarium oxysporum f. sp. niveum growth. Biotechnol. Biotechnol. Equip. 2019, 33, 1042–1052. [Google Scholar] [CrossRef]
- Zhou, H.; Ren, Z.H.; Zu, X.; Yu, X.Y.; Zhu, H.J.; Li, X.J.; Zhong, J.; Liu, E.M. Efficacy of plant growth-promoting bacteria Bacillus cereus YN917 for biocontrol of rice blast. Front. Microbiol. 2021, 12, 684888. [Google Scholar] [CrossRef]
- Xu, W.; Yang, Q.; Yang, F.; Xie, X.; Goodwin, P.H.; Deng, X.; Tian, B.; Yang, L. Evaluation and genome analysis of Bacillus subtilis YB-04 as a potential biocontrol agent against Fusarium wilt and growth promotion agent of cucumber. Front. Microbiol. 2022, 13, 885430. [Google Scholar] [CrossRef]
- Yang, R.X.; Ye, X.Y.; Liu, P.; Li, J.; Lu, M.M.; Wang, Z.H.; Shao, D.K. Endophytic Bacillus amyloliquefaciens Mdgb15 is a potential biocontrol agent against tree peony gray mold caused by Botrytis cinerea. Eur. J. Plant Pathol. 2024, 169, 431–445. [Google Scholar] [CrossRef]
- Luo, C.; Liu, X.; Zhou, H.; Wang, X.; Chen, Z. Nonribosomal peptide synthase gene clusters for lipopeptide biosynthesis in Bacillus subtilis 916 and their phenotypic functions. Appl. Environ. Microbiol. 2015, 81, 422–431. [Google Scholar] [CrossRef] [PubMed]
- Park, Y.J.; Kim, Y.J.; Yu, H.H.; Lee, N.; Paik, H. Cell-free supernatants of Bacillus subtilis and Bacillus polyfermenticus inhibit Listeria monocytogenes biofilm formation. Food Control 2023, 144, 109387. [Google Scholar] [CrossRef]
- Wang, X.; Onchari, M.M.; Yang, X.; Xu, L.; Yin, X.; Wan, F.; Chen, Y.; Guan, M.; Li, B.; Luo, C. Genome analysis of Bacillus subtilis JCL16 and the synergistic relationship among its metabolites reveal its potential for biocontrol of Nocardia seriolae. Biol. Control 2022, 167, 104855. [Google Scholar] [CrossRef]
- Zhang, J.; Gao, M.; Luo, J.; Guo, Y.; Bao, Y.; Yang, T. Antibacterial activity and mechanism of phillyrin against selected four foodborne pathogens. Food Sci. Technol. 2022, 42, e32922. [Google Scholar] [CrossRef]
- Wen, T.; Ding, Z.; Thomashow, L.S.; Hale, L.; Yang, S.; Xie, P.; Liu, X.; Wang, H.; Shen, Q.; Yuan, J. Deciphering the mechanism of fungal pathogen-induced disease-suppressive soil. New Phytol. 2023, 238, 2634–2650. [Google Scholar] [CrossRef]

| Strain | m-4 | a-3 | m-6 | m-1 |
|---|---|---|---|---|
| Bacillus velezensis | 43.45 ± 2.39 | 69.9 ± 1.93 ** | 35.99 ± 5.61 ** | 47.43 ± 2.22 ** |
| Bacillus subtilis | 44.63 ± 2.63 | 59.58 ± 1.32 | 27.41 ± 4.49 | 34.24 ± 3.67 |
| Bacillus amyloliquefaciens | 43.16 ± 2.59 | 51.11 ± 1.92 | 25.24 ± 4.16 | 41.38 ± 4.88 |
| Characteristic | Result | Characteristic | Result |
|---|---|---|---|
| Shape | Short rod | Maltose | + |
| Cell size (μm) | 0.4 × 0.6–1.0 × 3.0 | Lactose | + |
| Mobility | + | Xylose | − |
| Aerobic | + | Cellulose | − |
| Gram Staining | + | H2S | − |
| Citrate | + | Methyl red | + |
| Gelatin liquefaction | + | Amylohydrolysis | + |
| Calcium phosphate | − | Siderophore | + |
| Iron (iii) phosphate | − | Lecithin | − |
| Aluminium phosphate | − | Indole acetic acid | + |
| Casein | + |
| Lipopeptides | Mode | Current Experimental Mass | Previously Reported Mass | References |
|---|---|---|---|---|
| Surfactin | [M+H]+ | 1022.68, 1036.68, 1050.07/1051.07 | 1022.67 | Toral. et al. (2018) [24] |
| Iturin | [M+H]+ | 1043.55/1044.55 | 1043.50 | Zhao. et al. (2018) [25] |
| Fengycin | [M+H]+ | 1449.79, 1463.80, 1477.82, 1491.83 | 1491.84 | Toral. et al. (2018) [24] |
| Bacillaene | [M+H]+ | 567.03, 581.70 | 581.50 | Xu. et al. (2014) [26] |
| Treatment | CK | A | B | C | D | E |
|---|---|---|---|---|---|---|
| Inoculum concentration | 1 mL | 1 mL | 1 mL | 1 mL | 1 mL | 1 mL |
| PDB | 17 mL | 17 mL | 17 mL | 17 mL | 17 mL | 17 mL |
| Extract | 0 mL 0.0 C | 2 mL 0.2 C | 2 mL 0.2 C | 2 mL 0.1 C | 2 mL 0.05 C | 4 mL 1.0 C |
| Sterile water | 2 mL | 0 mL | 0 mL | 0 mL | 0 mL | 0 mL |
Disclaimer/Publisher’s Note: The statements, opinions and data contained in all publications are solely those of the individual author(s) and contributor(s) and not of MDPI and/or the editor(s). MDPI and/or the editor(s) disclaim responsibility for any injury to people or property resulting from any ideas, methods, instructions or products referred to in the content. |
© 2024 by the authors. Licensee MDPI, Basel, Switzerland. This article is an open access article distributed under the terms and conditions of the Creative Commons Attribution (CC BY) license (https://creativecommons.org/licenses/by/4.0/).
Share and Cite
Zhang, L.; Liu, Z.; Pu, Y.; Zhang, B.; Wang, B.; Xing, L.; Li, Y.; Zhang, Y.; Gu, R.; Jia, F.; et al. Antagonistic Strain Bacillus velezensis JZ Mediates the Biocontrol of Bacillus altitudinis m-1, a Cause of Leaf Spot Disease in Strawberry. Int. J. Mol. Sci. 2024, 25, 8872. https://doi.org/10.3390/ijms25168872
Zhang L, Liu Z, Pu Y, Zhang B, Wang B, Xing L, Li Y, Zhang Y, Gu R, Jia F, et al. Antagonistic Strain Bacillus velezensis JZ Mediates the Biocontrol of Bacillus altitudinis m-1, a Cause of Leaf Spot Disease in Strawberry. International Journal of Molecular Sciences. 2024; 25(16):8872. https://doi.org/10.3390/ijms25168872
Chicago/Turabian StyleZhang, Li, Zirui Liu, Yilei Pu, Boyuan Zhang, Boshen Wang, Linman Xing, Yuting Li, Yingjun Zhang, Rong Gu, Feng Jia, and et al. 2024. "Antagonistic Strain Bacillus velezensis JZ Mediates the Biocontrol of Bacillus altitudinis m-1, a Cause of Leaf Spot Disease in Strawberry" International Journal of Molecular Sciences 25, no. 16: 8872. https://doi.org/10.3390/ijms25168872
APA StyleZhang, L., Liu, Z., Pu, Y., Zhang, B., Wang, B., Xing, L., Li, Y., Zhang, Y., Gu, R., Jia, F., Li, C., & Liu, N. (2024). Antagonistic Strain Bacillus velezensis JZ Mediates the Biocontrol of Bacillus altitudinis m-1, a Cause of Leaf Spot Disease in Strawberry. International Journal of Molecular Sciences, 25(16), 8872. https://doi.org/10.3390/ijms25168872

